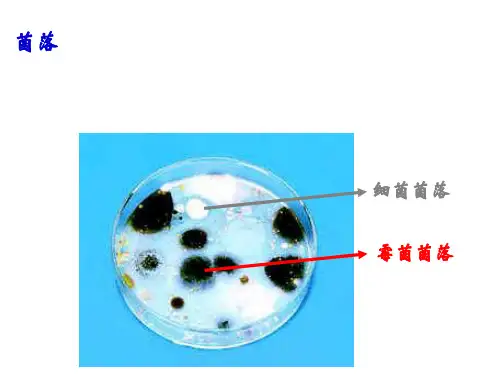

第3节 真菌
- 格式:docx
- 大小:25.25 KB
- 文档页数:2


第三节真菌一、真菌的种类1、通常分成三类:酵母菌、霉菌和蕈菌(大型真菌)2、举例:1)霉菌:是丝状真菌的俗称,意即"发霉的真菌",它们往往能形成分枝繁茂的菌丝体,但又不象蘑菇那样产生大型的子实体。
在潮湿温暖的地方,很多物品上长出一些肉眼可见的绒毛状、絮状或蛛网状的菌落,那就是霉菌。
青霉、曲霉、毛霉、根霉等。
2)酵母菌:酵母营专性或兼性厌氧生活,未知专性厌氧的酵母,在缺乏氧气时,发酵型的酵母通过将糖类转化成为二氧化碳和乙醇(俗称酒精)来获取能量。
茶酵母、啤酒酵母、面包酵母等。
3)蕈菌:xùn是指能形成大型的子实体或菌核组织的高等真菌类的总称。
双孢蘑菇、木耳、银耳、香菇、平菇、草菇、金针菇和竹荪。
二、真菌的繁殖1、真菌主要用孢子繁殖后代,在青霉和曲霉直立状态的菌丝顶端,分别生有绿色和黑色的孢子。
2、当真菌的营养生活进行到一定时期时,就开始转入繁殖阶段,形成各种繁殖体即子实体。
真菌的繁殖体包括无性繁殖形成的无性孢子和有性生殖产生的有性孢子。
3、无性繁殖无性繁殖的基本特征是营养繁殖通常直接由菌丝分化产生无性孢子。
无性孢子的类型:(1)游动孢子:形成于游动孢子囊内,无细胞壁,具1~2根鞭毛,释放后能在水中游动。
(2)孢囊孢子:形成于孢囊孢子囊内,有细胞壁,无鞭毛,释放后可随风飞散。
(3)分生孢子:产生于分生孢子梗上,顶生、侧生或串生,形状、大小多种多样,单胞或多胞,无色或有色,成熟后从孢子梗上脱落。
4、有性生殖多数真菌由菌丝分化产生配子囊,通过雌、雄配子囊结合形成有性孢子。
分为质配、核配、减数分裂三个时期。
经过有性生殖,真菌可产生四种类型的有性孢子。
5、制作孢子印6、食用菌的养殖7、鉴别毒蘑菇小结:真菌的主要特征1.既有个体微小的种类,也有个体较大的种类,细胞内有真正的细胞核。
2.细胞内没有叶绿体。
3.能产生孢子,孢子能够发育成新个体。
小结:。

【预习案】(一)各种各样的真菌1、在日常生活中,我们常常看到真菌中的霉菌使食品发霉。
其实真菌并不都是有害的,有些可以用来制作豆豉、腐乳、酱油等食品,我们平时吃的香菇、牛肝菌、木耳、银耳等,也是。
2、除了蘑菇,真菌中也有一些个头小的多的的个体(如青霉),还有的个体,如酵母菌。
(二)真菌的结构3、酵母菌细胞有,还有、、、等,和酵母菌一样,霉菌、蘑菇等真菌的细胞里都有。
真菌和动植物都属于。
4.组成青霉的菌丝有两种:在营养物质表面向上生长的,叫;深入到营养物质内部的,叫。
营养菌丝能够从营养物质内部吸收,供霉菌利用。
与细菌一样,真菌细胞内也没有,只能利用现成的生活。
(三)真菌的生殖5、在青霉直立菌丝的顶端,生有绿色的。
这些孢子可以飘散到各处,每个孢子在适宜的环境条件下,都能发育成一个新个体。
蘑菇也是用繁殖的。
可见,真菌可以通过产生大量的来繁殖后代。
6.真菌的特征是:既有单细胞的个体,如 ,也有多细胞的个体,如,细胞内有的细胞核;能够产生, 能够发育成新个体;细胞内叶绿体,营养方式为。
【列出我的疑惑】【探究案】1.比较细菌和真菌的不同点2.真菌以及大多数细菌的营养方式中,你能否说出这二者在生态系统中所扮演的角色?【我的知识网络图】【训练案】一、选择题1.以下各种真菌中,属于单细胞结构的是()A.青霉.B曲霉C.酵母菌D.木耳2、下列不属于真菌的是()ABCD3、真菌比细菌结构复杂之处是()A.真菌的细胞结构有细胞壁、细胞膜、细胞质B.真菌细胞内含有叶绿素C.真菌细胞内含有成形的细胞核D.真菌都是多细胞生物4、如右图所示的蘑菇的生殖方式是( )A.营养生殖 B.孢子生殖C.出芽生殖 D.种子生殖5. 下列组合中属于真菌的是()A. 银耳、香菇、酵母菌、曲霉B. 酵母菌、曲霉、大肠杆菌、猴头菇C. 曲霉、木耳、乳酸菌、蘑菇D.肺炎双球菌、青霉、葡萄球菌、牛肝菌6、下列生物不能产生孢子的是( )A.细菌 B.酵母菌 C.霉菌 D.蘑菇二、问答题青霉的菌丝包括哪几种?个有什么作用?三、填空题下图是蘑菇的形态结构示意图,根据自己学过的知识,试着完成有关问题:(1)请标出图中每一部分的结构名称(2)整个地上部分合起来叫做__________,[4]是它的地下部分,它的作用是__________________,所以蘑菇的营养方式是__________。





第五单元生物圈中的其他生物第四章分布广泛的细菌和真菌第三节真菌●教学目标学问目标1.了解各种食用或药用真菌的形态。
2.识记青霉、曲霉的外形构造、养分方式和生殖方式。
3.描述真菌的主要特征。
力量目标1.通过观看青霉、曲霉的形态、颜色,及颖蘑菇的形态,提高观看力量。
2.通过制作孢子印,提高动手操作力量。
情感目标通过本章的学习,激发学生树立生态学的观点,生疏保护环境的重要性。
●教学重点1.真菌的外形构造、养分方式和生殖方式。
2.描述真菌的主要特征。
●教学难点1.怎样识别青霉和曲霉2.如何制作孢子印3.真菌的生殖方式●教学方法观看法、图示法、试验法●教具预备:蘑菇、木耳、腐败的桔子,发霉的面包●课时安排:1 课时●教学过程[复习提问,导入课]教师:用谈话法与学生共同简要复习七年级有关真菌的学问。
有哪些同学知道馒头、面包的发酵需要哪一种菌类?学生:酵母菌,它是真菌的一类,是一类单细胞种类。
教师:依据你们查阅的资料,知道真菌还有哪些种类,看谁知道得多,并准时赐予鼓舞。
学生:蘑菇、木耳、灵芝、猴头。
学生:还有青霉、曲霉等。
教师:同学们答复得格外好,在日常生活中,我们食用蘑菇、木耳、香菇等养分价值很高的真菌;但我们也常常为桔子长毛、馒头长毛、衣物发霉而苦恼;这些令我们既爱又恨的真菌分别有哪些形态构造特点和特征呢?这就是本节课我们要探讨的内容。
〔几种真菌的投影〕[创设情境,开放课]〔学生活动〕观看、生疏、争论、说知名称有木耳、牛肝菌、香菇、灵芝、银耳、口蘑、猴头菌等。
教师:同学们认得很对,有哪位同学情愿给大家介绍一下它们有哪些养分价值和药用价值呢?学生:例如香菇,它含有人体必需的 7 种氨基酸,蛋白质含量比一般蔬菜、水果多,还含有钙、铁、锰等人体必需的矿质元素。
学生:在古代,传奇灵芝具有起死回生的妙用,是一种使人长生不死的灵丹妙药,这固然是没有科学依据的,但它的药用价值确实很高。
教师:太棒了,告知教师你们是怎样知道的。
第三节真菌01知识管理1.各种各样的真菌几种常见的真菌:牛肝菌、香菇、木耳、青霉等。
2.真菌的结构酵母菌的结构示意图:酵母菌结构:酵母菌的细胞都有细胞壁、细胞膜、细胞质、细胞核、液泡等。
青霉的结构图:青霉结构:组成青霉的菌丝有两种,在营养物质表面向上生长的叫直立菌丝;深入营养物质内部的叫营养菌丝。
青霉的细胞内没有叶绿体,只能靠营养菌丝从营养物质内吸收有机物,因此,其营养方式是异养。
蘑菇的结构图:蘑菇的结构:蘑菇结构分为地上和地下部分,地上部分由菌柄和菌盖组成;地下部分由菌丝构成。
3.真菌的生殖及特征生殖:真菌可以通过产生大量的孢子来繁殖后代。
注意:①不只是真菌利用孢子来繁殖后代,藻类、苔藓、蕨类植物都是利用孢子来繁殖后代;②细菌的芽孢与真菌的孢子不是一回事。
芽孢是一种休眠体,是某些细菌生长到一定阶段在细胞内形成的一种结构,常常用来抵抗外界不良环境。
而且它在适宜的条件下也能发育成新个体,一个芽孢只能产生一个营养体。
而孢子就是一种繁殖体了。
它是专门的生殖细胞,正常情况下不需要两两结合就能单个发育成一个个体。
主要特征:既有单细胞的个体,如酵母菌,也有多细胞的个体,如蘑菇,细胞内有成形的细胞核;能够产生孢子,孢子能够发育成新个体;细胞内没有叶绿体,营养方式为异养。
知识点拨:细菌和真菌的区别02例题解读【例1】(衡阳中考)“得了灰指甲,一个传染俩”。
灰指甲学名甲癣,是一种由真菌感染而引起的传染性疾病。
真菌细胞与细菌相比结构上最主要的区别是具有() A.细胞壁B.细胞膜C.遗传物质D.成形的细胞核【解析】细菌细胞的基本结构为细胞壁、细胞膜、细胞质、未成形的细胞核;真菌细胞的结构具有细胞壁、细胞膜、细胞质、细胞核。
所以真菌细胞与细菌相比结构上最主要的区别是具有成形的细胞核。
【答案】 D【例2】(泰安中考)夏天,受潮的粮食和皮鞋常常发霉,这些霉菌是由哪种结构发育而来()A.孢子B.菌丝C.芽孢D.子实体【解析】真菌不是自然产生的,这些真菌都是由空气中孢子来繁殖后代。
第三节真菌
【教学目标】
【知识目标】
1.认识日常生活中常见的真菌,分析它们与人类的关系。
2.识记青霉、酵母菌的形态结构、营养方式和生殖方式。
3.描述真菌的主要特征。
【能力目标】
1.通过观察青霉、酵母菌的形态、颜色及新鲜蘑菇的形态,提高观察能力。
2.通过制作孢子印,提高动手操作能力。
【情感态度价值观】
通过学习,培养学生树立生态学观点,认识保护环境的重要性。
【教学重(难)点】
真菌的主要特征、真菌的营养和生殖方式。
【课前准备】
酵母菌培养液、培养好的青霉、吸管、镊子、显微镜、解剖针、载玻片、盖玻片、放大镜、碘液、吸水纸、新鲜的蘑菇供学生制作孢子印、多媒体课件等。
【课时安排】1课时
【教学过程】
一、情境导入
出示新鲜的蘑菇、木耳、银耳、酵母菌包装袋等物,引入新课。
二、新课教学
(一)观察酵母菌
1.播放临时玻片的制作过程,组织学生制作酵母菌的临时玻片。
2.播放显微镜的使用方法,学生使用显微镜观察酵母菌。
提示学生:注意观察酵母菌的形态、颜色、细胞结构及芽体。
(二)观察青霉
1.指导学生使用放大镜观察青霉的直立菌丝及孢子的颜色。
2.指导学生使用显微镜观察青霉孢子的着生状态及孢子的颜色。
(三)观察蘑菇
1.说出蘑菇的各部位的名称。
2.观察蘑菇的菌褶及孢子。
(四)真菌的细胞结构
指导学生阅读教材有关内容:
1.说出真菌细胞的结构及营养方式。
2.了解霉菌菌丝的分类及作用。
(五)真菌的繁殖方式
指导学生观察自己制作的孢子印,阅读课文,提出问题:
1.蘑菇孢子的位置、数量、形态及作用是怎样的?
2.真菌通过什么来繁殖后代?
3.真菌的孢子在什么样的环境下,才能发育成新个体?
4.了解真菌的繁殖特点,对于我们有什么意义?
学生阅读、观察、讨论、表达交流。
三、课堂小结
将细菌、真菌的各项特征进行对比。
四、课后提升
请认真阅读下列短文,并回答有关问题。
一粒“尘埃”悄悄地落在一只蟋蟀的背上,细长而闪亮的丝线从“尘埃”中伸出来,开始进入蟋蟀湿润的身体。
在它们生长时,这些丝线还释放一些化合物,慢慢地溶解蟋蟀体内的组织。
这些丝线还进一步深入蟋蟀的体内。
数日后,这只蟋蟀就成为一只塞满致命丝线的空壳。
然后这些丝线开始向这只死蟋蟀体外延伸。
它们长出柄,并且在顶端生有结状物。
一旦一个结状物裂开,就会有数千粒尘埃般的微粒散发出来,风将带着它们再次去“犯罪”。
(1)文中所说的“尘埃”指的是孢子;“丝线”指的是菌丝。
(2)这种神秘的“尘埃”以及它内部长出的“丝线”,与蟋蟀是什么关系?
蟋蟀为神秘的“尘埃”以及它内部长出的“丝线”提供有机物。
(3)你认为使蟋蟀致死的是哪种生物?
真菌。